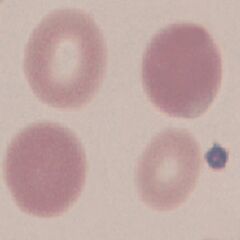

Dimorphic
From haematologyetc.co.uk
Derivation: From Greek di- ‘twice’ + morphē ‘form’
Appearance
The occurrence of two populations of circulating erythrocytes that have different morphological features. Generally (but not exclusively), a fairly normal population co-exists with an abnormal population (characterised by different colour, size, and/or shape).
'
Images The most typical appearance of dimorphic erythrocytes has normal cells with a small area of central pallor and a microcytic hypochromic population, this is also shown on the clinical image. However many other dimorphic appearances are possible.
Significance
A true dimorphic appearance (two entirely distinct populations). This usually arises from one of a limited range of reasons (see Causes).
Pitfalls
Many disorders that affect red cells (either through disordered production or through damage in the circulation) can cause mixed appearances with some cells being more severely affected. However, these generally cause a spectrum of appearances with transitional forms between the normal and the abnormal cells. A true dimorphic population should not have overlapping appearances.
1. Causes
| Transfused red cells |
|---|
| Probably the most common cause encountered in the laboratory. Transfused blood cells co-exist with diseased cells. The transfused cells have a normocytic normochromic appearance, while the abnormal erythrocytes differ (having the characteristics of the underlying disorder e.g. microcytic hypochromic cells). |
| Treated nutritional disorder |
| Where abnormal red cells result from a readily reversible cause (e.g. iron deficiency or megaloblastic anaemia), newly-formed normal cells will coexist with the abnormal cells for a period of time e.g. normocytic normochromic cells circulate together with microcytic hypochromic cells in early phase after treatment for iron deficiency. |
| Clonal bone marrow disease |
| A dimorphic blood film is typical of sideroblastic anaemia (although this is not always seen). In this disorder the bone marrow produces two distinct cell forms that circulate together. Typically,a hypochromic-microcytic population is seen together with a normochromic-normocytic population. |
2. Clinical Examples
Clinical Image 1 An underlying iron deficiency state is indicated by the majority cell type that is small with an increased area of central pallor. There are less frequent large cells with darker staining and less (or absent) central pallor. The latter cells are transfused (stored red cells often become non-discoid and may lack central pallor shortly after transfusion).
Clinical condition: iron deficiency with transfused cells